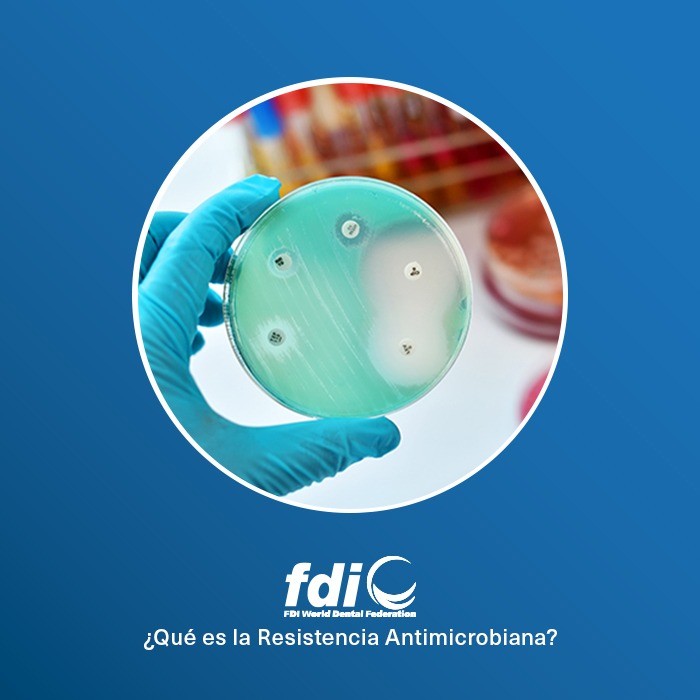

21-12-2021
Poco después del lanzamiento del sistema de pilares CONNECT, hace algo más de dos años, los equipos de gestión de
Ver Más
02-12-2021
El sistema de pilares CONNECT es una solución amplia y completa, que ofrece a los odontólogos la posibilidad de maximizar
Ver Más
18-11-2021
Al finalizar el verano de 2019, el equipo de expertos de MIS, también conocido como MEET, se reunió en la
Ver Más
10-11-2021
MIS ha presentado su nuevo avanzado sistema de anclaje LOCKiT para sobredentaduras implantosoportadas. Con una esperanza de vida cada vez
Ver Más
01-04-2020
Conoce las características que hacen al implante C1 ideal para carga inmediata. Mecanismo de Doble Estabilidad El C1 cuenta con
Ver Más
02-10-2019
La previsibilidad es uno de los principales retos que influyen en la práctica diaria como especialista, es por esto, que
Ver Más
26-09-2019
La Asociación Europea para la Osteointegración EAO celebra su 28 reunión científica en Lisboa, del 26 al 28 de septiembre
Ver Más
11-09-2019
Una vez más, puedo confirmar que mi combo favorito: 4MATRIX, OSSIX PLUS y Melatonina bien manejados y en los casos en los
Ver Más
05-08-2019
El branding personal para odontólogos es un concepto en el cual un especialista de la salud se define igual que
Ver Más
26-07-2019
A pesar de que muchas de las redes sociales se utilizan para entretenimiento, la realidad es que también pueden ser
Ver Más
22-07-2019
Se abre la convocatoria para el concurso de casos clínicos del 5to MIS Global Conference a celebrarse en Marrakech, Marruecos
Ver Más
15-07-2019
¿Qué es la Resistencia Antimicrobiana? La Resistencia Antimicrobiana (RAM) es una amenaza importante para la salud y la seguridad humana.
Ver Más
11-07-2019
Estamos encantados de anunciar que hemos modificado y ampliado la gama del sistema CONNECT. El nuevo y mejorado sistema incluye
Ver Más
01-07-2019
Este es el reflejo histopatológico de lo que vivimos practicamente a diario los odontólogos; procesos inflamatorios crónicos asociados a ápices
Ver Más
18-06-2019
La forma triangular única del cuello del implante V3 da como resultado menos titanio y deja espacio adicional para más
Ver Más
28-05-2019
Con el objetivo de facilitar la difusión y conocimiento de los principales argumentos y medidas que contempla la nueva clasificación
Ver Más
20-05-2019
“Existe una clara asociación entre enfermedad periodontal y enfermedad cardiovascular”, asegura el Dr. Juan José Gómez Doblas, presidente de la
Ver Más
09-05-2019
La superficie MIS B+ cuenta con un componente biológico, que da como resultado una osteointegración efectiva a largo plazo. Una capa
Ver Más
25-04-2019
El sistema EZ-Base cuenta con un exclusivo Ti-Base, diseñado con un canal y un tornillo altamente accesible para una angulación
Ver Más
22-04-2019
Les recomendamos descargar la Revista de la Sociedad Española de Periodoncia SEPA, que en la edición 2017/01 tiene un artículo
Ver Más
12-04-2019
El Connect permite que todo el procedimiento protésico y la restauración se produzcan lejos del hueso y en cualquier nivel
Ver Más
03-04-2019
El cemento para regeneración ósea 4MATRIX es un innovador producto sintético, desarrollado con el fin de simplificar los procedimientos de
Ver Más
14-03-2019
Como parte de nuestra oferta de prótesis guiadas por computadora, creamos el nuevo servicio de integración perfecta en el flujo
Ver Más
07-03-2019
Los invitamos al concurso de casos clínicos del XIV Simposio MIS Colombia, qué se llevará a cabo el 6 de
Ver Más
01-03-2019
El futuro de la Odontología Digital… es hoy MIS proporciona servicios completos de soluciones digitales MCENTER. Los especialistas pueden llegar a
Ver Más
28-02-2019
¿Realmente conocemos cómo se lleva a cabo el proceso de producción y el control de calidad de los implantes? Los
Ver Más
19-02-2019
El Día Mundial de la Salud Bucodental, se celebra cada año el 20 Marzo desde el 2013, esta organizado por
Ver Más
13-02-2019
Esta evolución incorpora el concepto de cambio de plataforma, que ha demostrado una reducción considerable de pérdida ósea crestal y está orientado
Ver Más